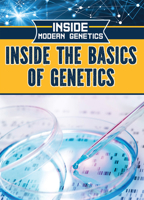
Inside the Basics of Genetics 1499470444 Book Cover

Inside Delta Force
$5.99

Inside the Army Rangers
$32.27

Inside Marine Force Recon
$32.27

Inside DNA and RNA
$33.69
Inside the Basics of Genetics
Out of Stock

Beware the Blue-Ringed Octopus!
$16.85

Beware the Box Jellyfish!
$16.85 - $26.49

Beware the Puffer Fish!
Out of Stock

Poisonous Creatures Set
$80.62 - $155.76

UCT Under Apartheid: From Onset to Sit-In: 1948–1968
Out of Stock

Inside the Green Berets
$11.09 - $32.27

O Chamado de Cthulhu - H. P. Lovecraft: + marcador de páginas
Out of Stock

Lovecraft - Sussuros Na Escuridão e Outros Contos Extraordinários
Out of Stock

Lovecraft - O Horror De Dunwich e Outros Contos Extraordinários
Out of Stock

U.s. Special Ops Forces
$69.60

Inside Pararescue
$32.27

Inside the Navy Seals
$32.27

Inside the Army Rangers
Out of Stock

Inside Pararescue
Out of Stock

Inside the World of Microbes
Out of Stock

Epidemics: The Story of South Africa's Five Most Lethal Human Diseases
$26.39

The Next Four Years: A Vision of Victory
Out of Stock

Moscow's Challenge to U.S. Vital Interests in Southern Africa
Out of Stock

The Cape Doctor in the Nineteenth Century: A Social History (Clio Medica, 74)
$65.00

Inside the Green Berets
Out of Stock